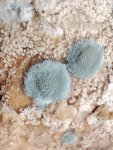

Понятно, ты пидр
Я не пидорас блять!Может ты пидорас?За базар ответишь?
Зачем ты приносишь своего протыка?А?Пидорасина?
Насрал тебе на ебасос, питух.
Опущение, ебаный, пади на порашу, чмо.
По какой статья чалился петушатник?Не в масть тебе такой нести, чучело подзаборное.
Фу блять, старый гомодед, как меня тошнит от такого пидорства.
Так я тебя лично опускал, у тебя до сих пор сперма из очка льётся
Ты ахуела петушинная масть?Тебя всем централом в сраку ебали без остановки.
Кукарекает петушок
Одна гомосятня тут сидит, есть ли тут нормальные крепкие мужики которые давят гомосятню?
Все поголовно кроме тебя, тут каждый давил тебе в очко
Ролл
Набрал 7 из 20, я пидор?
Ты просто пидорасище, оттрахать и обкончать!
1.Бреет хуй/подмышки да
2.Длинные волосы нет
3.Носит серёжки нет
4.Ухаживает за телом нет
5.Использует дезодорант да
6.Дрочишь на порно где мужик ебет бабу да
7.Не интересуешься мужскими интересами(автомобили,рыбалка,бухалово) хуета ебаная как и футбол
8.Пьешь как баба пью как старый дальнобойщик
9.Не ходит на турнички подтягуиваюсь дома
10.Не слушает рэп(ак47,ноганно,каста,баста) хуета
11.Курит тонкие сигареты нет
12.Курит сигареты с фильтром нет
13.Смотрит аниме/прочие мультики для детей аниме да
14.Не умеет водить да
15.Не умеет рыбачить да
16.Не умеет забивать гвозди умею, кое что понимаю в стройке вообще
17.Интересуется бабскими штучками нет
18.Говорит как пидор нет
19.Не ебал бабу ебал шлюх
20.Не может постоять за себя Да я трус немного, пытаюсь избегать конфликтов
Пидорасинка.Голубятня ждет тебя!
Хуйню спизданул. Это в голливудских фильмах из 80s[ геи такие, а ирл он скорее будет еще более мужиковатым, чем ты.
Вот когда твой друг будет помогать тебе сменить карбюратор, тогда-то кто-то кого-то и отпердолит в пукан.
А ты - быдло простое.
>Вот когда твой друг будет помогать тебе сменить карбюратор, тогда-то кто-то кого-то и отпердолит в пукан.
>А ты - быдло простое.
Среди моих корешей нет пидорья, ровные типы, а ты че, пидораска?
Двачую. Меня батин корешь выебал в бане, вообще не ожидал такого. Суровый такой мужик, крепкий, трое детей, говорят бабник лютый, а тут все ушли, он подкатил и прам пам пам. Такие дела.
> Среди моих корешей нет пидорья
А тебе откуда знать? Да и с какой стати кто-то будет что-то доверять такому, как ты?
Судя по тому, что ты пишешь, ты настоящих геев видел только в кино и сериалах.
Потому что они ровные пацаны, не гони бочку на моих пацанов!Если ты пидор, то это не значит что они тоже пидоры.
Хорошо что обозначился.
Это для тебя они просто "ровные пацаны".
Ты ахуела шваль?Есть сомнения в моих словах?Может ты петух?Хотя по тебе видно, опущенный пидорочееек!
Да ты не беспокойся. Правды ты всё равно никогда не узнаешь. Разве что только вместе со всеми.
Я тебя легко обозначу в пидоры
ОП - ущенный
Закукарекала петушня - день прошел не зря.
С тобой - каждый день праздник.
>1.Бреет хуй/подмышки
Может, у тебя на самом деле на половом члене растут волосы, что довольно смешно. А лобок я не брею. Мужчины с волосатым животом, бедрами, и сверкающим бритым лобком смотрятся, как посмешище.
Бритьё - прошлый век.
Эпиляция. Причем сосков, груди, живота и бедер. На голенях можно проредить волосы.
>2.Длинные волосы
Стиль томбоечки более интересен. Зачем выглядеть, как жирный металлист, или Залдостанов?
>3.Носит серёжки
Только одну. В уздечке полового члена.
>4.Ухаживает за телом
А то!
>5.Использует дезодорант
Конечно!
>6.Дрочишь на порно где мужик ебет бабу
Фу, такое смотреть!
>7.Не интересуешься мужскими интересами(автомобили,рыбалка,бухалово)
Ну уж нет. Искусство, живопись, балет, танцы.
>8.Пьешь как баба
Алкоголь для быдла.
>9.Не ходит на турнички
Турники? И как я на твоих турниках буду качать ягодицы?
>10.Не слушает рэп(ак47,ноганно,каста,баста)
Кто такие?
>11.Курит тонкие сигареты
>12.Курит сигареты с фильтром
Это для быдла
>13.Смотрит аниме/прочие мультики для детей
Это для небыдла.
>14.Не умеет водить
Меня возят туда, куда мне нужно. Впрочем, я умею водить велосипед.
>15.Не умеет рыбачить
Пробовал два раза в жизни.
>16.Не умеет забивать гвозди
Забью как нехуй делать
>17.Интересуется бабскими штучками
Они и сейчас на мне...
>18.Говорит как пидор
Фу...
>19.Не ебал бабу
И бабу, и мужчину, и баба меня, и мужчина меня, и пара. Вот, с собакой и двачером не было.
>20.Не может постоять за себя
А как?
Думаю что ты не пидорас, а эстет!
Не кукарекай, пидорашка проткнутая.
Эстет пидорастии!!!
оп, откуда тебе известны признаки пидорасов? ты что, общаешься с пидорами? или ты может вовсе латент?
Воры в законе спустили методичку.
что то какие то подозрительные авторитеты, больно много знают о пидорстве
Самый умный?Или петух?
Бля, нахуя вы на серьезе отвечаете боту? Или вы тоже боты? Сука двач 2026
не-не, базару ноль, мне только непонятно откуда столько знаний о пидорасах
Я не бот, а ты пидор!Лахты не существует.
Самый умный?Или петух?
Нужно соответствовать всем критериям или достаточно одного?
да все-все, отстал, не петух я
Если есть хотя бы один критерий - ты пидорас, чем больше критериев то тем более ты пидороватый!
А то!
Слишком заумные вопросы задаешь.Общайся по людски!
Ты шлюха!Как будущая мать может постить свою пизду итт?
Соевого пидора порвало, и он решил максимизировать иронию. Но ты не с теми борешься, пидорашки друг с другом срутся, потому что вас барины ебут и за ниточки дёргают.
ну и нах ты кукарекаешь
Погоди. Т.е. ты считаешь, что есть оттенки пидорства? Можно быть слегка пидорасом или, как противоположность, конкретным таким мазровым пидорасом. Так что-ли?
Все так, два чифира опу
Ты не лахта, а просто бот для поддержания жизни этой ебаноц борды. Слава России Z
Ого! Вот это да! Ай да ОП, ай да молодец!
Думаю есть градация, я конечно не кончал именнитых вузов по психологии или социологии, но считаю что есть пидор-нюфаня, а есть пидор-80lvlа.Но факт в том что они пидорки!!
А что порядочные пацаны должны делать с пидорами?
понял, не намеревался задеть, впредь буду тщательнее следить за словами
Че ты там кукарекаешь петушара?
Трахать, обоссывать и обхаркивать!Чтобы не допустить распространения гомосятни.
Я говорю, Слава России. Ты за это назвал меня петушарой? Ты вообще из какой страны? Крым чей?
ты почему патриота петухом назвал? и что ты путина значит тоже петухом считаешь? ты петух?
Оп хохол и пидарас, шлюху вывели на чистую воду
Отвечу пидорасам и прочим нетрадиционным.Я не из постсовка, надеюсь этого достаточно.Данный тред не про политику, а про пидорасов!
> шлюху вывели на чистую воду
Шлюха твой протык который ебёт тебя по ночам.
>1.Бреет хуй/подмышки
Петухан-чухан детектед.
>4.Ухаживает за телом
Обрыган-скуфан детектед.
>5.Использует дезодорант
Воняющий чухан детектед.
>7.Не интересуешься мужскими интересами(автомобили,рыбалка,бухалово)
Быдлан детектед.
>8.Пьешь как баба
Алкаш детектед.
>9.Не ходит на турнички
ЗОЖ головного мозга детектед.
>10.Не слушает рэп(ак47,ноганно,каста,баста)
Говноед детектед.
>14.Не умеет водить
Тазоёб детектед.
>15.Не умеет рыбачить
Бесполезный скилл детектед.
>18.Говорит как пидор
Слышь, ты ебало-то завали.
>19.Не ебал бабу
Пиздозависимый детектед.
У тебя комбо, петух.
11 попаданий ОП чё делать будем в этой ситуации?
Странная у тебя конечно логика. Чёткие критерии и явно размытая классификация пидоров по этим критериям. Какое-то пидоврирование. Ты сам-то не пидор часом?
За базар вывезешь петушара?По какой сидел?
Ты пидорас среднего уровня, вроде и нормальный пацан когда-то был, но с порванным очком от хуя.Уже ничего не сделаешь.
Не рвись, быдло. Сам перечень запостил, под котьрый подошёл.
xD
г
Дырявый, спок
СЛЫШИШЬ ТЫ!!! ВАФЛЯ ОТЪЕБАНАЯ!!!! ТЫ ПУТИНА УВАЖАЕШЬ ОТВЕТЬ НА МОЙ ВОПРОС ПИДАРАС!!! ТЫ ЗАЛУПА БЛЯ И ТЕРПИЛА Я ТЕБЯ НАЙДУ И В ОЧКО ОТТРАХАЮ С ПАХАНАМИ ТЫ ПОЧЕМУ ТАК ПРО РОСССИЮ ГОВОРИШЬ ХУЕСОС
А если не через кесарево родился?
ОП ШЛЮХА ДУРНАЯ ХОХЛЯТСКАЯ ЕГО ЕБАЛИ СКАКУАСЫ В ЖОПУ
С какого города? Хочу тебя в очко отпороть
Не рвись, быдла. Сам перечень запостил, под который подошёл.
xD
{фикс, сука}
Фу бляяяя, да ты пидорасина.Приезжай ко мне в Салоники, моя братва покажет что с пидорасами тут делают.
Кречет-ОПущ, спок.
умри хохол
Признаки пидораса.
1. Пишет тредэ с признаками пидораса
Так киприотов дохуя пидорасов. Лол. Может ты и сам говномес?
Древние греки все в жопу ебались, а ты в Греции живешь? Пидорасина блять
Терпай, сука. )
Пидорасы бляяя, вас не ебали давно чтоли?Че такие злые то, а, пидорасинки?😁😁😁
Заткнись шлюха
петушиный тред
Латентный, спок. Что случилось с твоим любовником, почему ты плачешь?
Да, давно. Можешь помочь?
Пидорье раскукарекалось, давно хуя в рот не брало😁😁😁
>
Дерзко чё то базаришь
Дерзко чё то базаришь
Пидоров для удовольствия не ебу, ебу только чтобы унизить!
За 19 пункт инцелы тебя выпиздят с двачей и проклянут.
ну так возьми хуй в рот и успокойся хохол
Ух давно. Можешь помочь?
Мне похуй на петухов-инцелов, пусть дрочат на баб с хуями.Я сижу тут с 2008 года, смеюсь над петушатней😁😁😁
Ауе-быдло, спок. На воле в рот шатали все твои понятия.
Просто инцел ищет в говне горошек.
Троллю ОПа под сажей.
И чё ты сделаешь?
Только пидоры их шатали, молодёж забыла про наставления воров.
А зачем ты тут сидишь? М? Нравится с петушками на одном насесте, а признать не можешь. Хехе
Я таких пидоров порицаю, смотри уже сколько пидорья вскукарекнуло!
> Признаки пидораса.
> Итт я напишу все признаки пидораса, если у себя нашел таковые то ты пидорасина которую нужно выебать и обхаркать!
1. Нет
2. Да. Пикрил
3. Нет
4. Нет
5. Нет
6. Нет
7. Блять хз. рейт мои интересы https://t.me/pacnugopaceHo и подписюйтесь. Это переходник потому что обезьянище пидарас
8. не пью этанол
9. Хожу
10. Говно для пидаров. Слушаю техно, хардбасс, хардкор, хардстайл
11. Как же блять заебала никотиновая зависимость. Курю пыхтелку, бычки, махру в самодельной трубке
12. См выше
13. Не смотрю. НЕ С КЕМ БЛЯТЬ
14. Дайте денег на права
15. Умею, но не люблю. Лучше воровать рыбу из чужих сетей
16. Умею
17. Это какими?
18. Это как
19. Это признак инцела, а не пидора
20. Я тебе в ебало дам
Каким образом ты их порицаешь?
Ебальник, один репорт за оскорбление Пу - и ты отлетаешь.
Осознавай что ты жив пока развлекаешь, клоун.
символичный петух в капче для тебя
Ты шлюха сука кроссдресерская, почему ты так стал, пидор?
Если сосёшь и ебёшь в жопу пацанов это не пидорство, главное чтобы тебя в жопу не ебали, хотя бы при всех.
Рейт мои жилища
Петушара комбовая, на ноль всё.
Ты лох, если сидел.
Попустись пидор, никто твоего протыка не трогает.
Саша Солоник, ты?..
Но тебя же братва в Греции ёбнула.
Поплачь
О, привет. Чёт ты редко начал посты делать. Что случилось?
Более реабельно чем высер опа долбаёба.
Совпало 13 пунктов, жду тебя на харч в твое ебало, только не обосрись плиз когда меня увидишь
>опущенный перед расстрелом Саша вещает из гроба
Депреся, шизонька, сожрали мой гаввах
Ты такие вещи про уважаемых людей не говори!Он не был пидором как ты!
Собакена потерял? Понимаю
Попец таблетки тогда что-ли
>ОПущенный перед расстрелом Саша Солоник вещает из гроба
{фикс, сука}
Успокойся. ОП уже убежал ранняя кал
А ещё переезд туда где жрут мой гаввах
Убежал ебать твою пидорскую жопу.Принимаешь, пидор?
Пиздишь, за 15 лет обезьяна поумнеет. Ты не обучаемый?
Олдфаг, а ты импотент?
У меня вот хуй стоит, сам примерно луркофаг 2012 года выпуска.
Вайпы ЦП и гомониграми помнеш?
>Олдфаг, а ты импотент?
На баб конечно стоит, но не на пидоров!
Терпай, сука. Чёрные зоны канули в прошлое.
Теперь все ссученные, все под кумом ходят.
Принял тебе защеку, пидар.
Ну ты и пидорина, сразу защеку берешь.
Потерял источник дофаминки давно ещë, потерял своего первого в жизни собакена пиздец стыдно перед ним до сих пор и корëжит, погряз кредитках благодаря другу зелëному и своей тупости
Так ты получается тоже пидор кольу тебя на волосатую мужскую жопу хуй встаёт. Ахаха0а0
Кто изнасиловал тебя на сей раз? Не кричи.
Встать может и без возбуждения, медицинский факт для пидораса.
Ну ты б хоть донатку какую у себя на канале оформил. Может кто подогревал рублем
А это ты пидор-велокурьер сломавший зуб, да?Нашел новый ляс?Или ты другой анон?
Может, только у больного наглухо латентного пилорама типа тебя
Говорю ещё раз, петушара, я пидоров без удовольствия ебу, чисто опустить.
Пошел нахуй
А хуй как встаёт тогда? Возбуждаешься от мужской жопы волосатой, да?
Ладно, спрошу по другому, ты этот анон или нет?Похожи просто.
Всей правды про ОПущенную жопу Саши Солоника мы теперь не узнаем.
Заказали убийство его очка кожаным пистолетом, так сказать.
На баб смотрю перед этим.
А гойблетки я жрал, от них дереализация ебучая. От мирты. От венлы я зеваю как чорт.
И денег нет нихуя
А волшебная жиженька только катализатор, если есть дофаминка то заебись колбасит, а если нет то ещë сильнее в депресеньку и рытьë в своих мыслях
Резюмируя: не пидор, это когда необразованный быдлан на кортах, вырастающий в подпивасного смазочника.
Да просто забавно как Саша Солоник из гроба пизди́т.
Хороший заказной киллер был мужик, но в итоге сам пошёл в расход в конце.
Ну чего ты ? Не вешай нос
Дед-пидооор.Санёк уже оттрахал его до беременности, также хочешь чтоли, фуу.
>1.Бреет хуй/подмышки
чек
>2.Длинные волосы
чек
>6.Дрочишь на порно где мужик ебет бабу
чек
>7.Не интересуешься мужскими интересами(автомобили,рыбалка,бухалово)
чек
>8.Пьешь как баба
с крепкого тошнит
>9.Не ходит на турнички
чек
>10.Не слушает рэп(ак47,ноганно,каста,баста)
чек
>13.Смотрит аниме/прочие мультики для детей
чек
>14.Не умеет водить
чек
>15.Не умеет рыбачить
чек
>18.Говорит как пидор
чек
>19.Не ебал бабу
чек
Ладно, развлекайтесь.
Сам пидор
Я ультранепидор
А тред у тебя латентно пидорский
Я сюда зашëл чисто вниманьку фармить
Что значит новый ляс? Я купил чертолёт но чëт с ним хуйня какая то выходит всë время
Скора. Но хуй знает поможет ли
Мы по самую жопу в кредитках и ррассрачках
За твою защеку беру и сливаю пидорасина
Значит ты другой анон по всей видимости.Но тебя тоже помню.
Хуй возьми, губой тряси, пидораскааааааа!🤣🤣🤣
Так ты ещё и дрочишь на то как баб ебут пидор.
Я дрочу на голых баб, ты за пидора меня держишь?
Не верю, что есть другие велокурьеры сломавшие зуб
У тебя было же 2-3 лясопеда и тебя наебывали на ремонт?Так?
Потряс тебе звщеку и мамке твоей в вонючую шмоньку пидораска визгливая.
Пидорасина визжит, иди протыка попроси оттрахать тебя.
Я за жопу тебя держу когда ебу, выключи дурака, тут все свои.
Маняфантазии пидора подоминировать, иди попроси протыка об этом, хз.
Маловероятно
И чиню себе всë сам
Пртык оттрахал тебя поэтому ты визжишь пидор.
Ты с собой путаешь, пидорина!
Пойду бабу трахну, не скучайте, петушки.
жирно
Попросил тебя ворот а протык в жопу тебя просит пидор визгливый.
R8
Путаю тебе защеку пидорасина
Иди иди, на порехаб трахать левой а потом правой рукой.
Сосать еще будешь.
Так пустили меня по кругу! Мой шансон моя братва! мимо оп
Так ты сам пидор опущенный, ты ебал бабу и лизал её пизду как пришибленный пиздой пиздораб. Тебе пиздой глаза зашило.
Натурал всегда мизогин и дрочит только на 2Д, поёбывая идеальных реалистичных кукол в ожидании андроидов.
А раз ты лизал пизду, значит и хуй сосал и в очко своё дырявое + волосатое давал. От пизды до хуя - один шаг, и ты его давно переступил. Ты даже свою аватарку к шапке прикрепил.
А уж репчик - это бесперебойный маркер пидора.
Подо мной пенис большой очень
Мы с пацанами членососим
Он мне присунет, пока дрочит
Член повышает градус в жопе
Подо мной пенис большой очень
Мы с пацанами членососим
Он мне присунет пока дрочит
Член повышает градус в жопе
Не вот правильные признаки:
1. Подстрижен не налысо или 0,3 см
2. Зубы не кривые или не гнилые и изо рта не воняет
3. Не слушает Макана и кальянный рэп
4. Считает что человек имеет право не быть избитым нашими южными согражданами или иностранными специалистами ни за что
5. Не лапает других пацанов за хуй по-братски при встрече
6. Не курит (или курит меньше 5 сигарет в день)
7. Не любит ебать петуха
8. Трогает предметы на которых петушиные атомы побывали
9. Дрочит на порно где только баба (без хотя бы хуя в кадре)
10. Моется хотя бы раз в неделю
11. Не хочет играть с пацанами в вертолет по-братски
12. Пьет что нибудь другое кроме водяры или балтики
бамп

Итт я напишу все признаки пидораса, если у себя нашел таковые то ты пидорасина которую нужно выебать и обхаркать!
1.Бреет хуй/подмышки
2.Длинные волосы
3.Носит серёжки
4.Ухаживает за телом
5.Использует дезодорант
6.Дрочишь на порно где мужик ебет бабу
7.Не интересуешься мужскими интересами(автомобили,рыбалка,бухалово)
8.Пьешь как баба
9.Не ходит на турнички
10.Не слушает рэп(ак47,ноганно,каста,баста)
11.Курит тонкие сигареты
12.Курит сигареты с фильтром
13.Смотрит аниме/прочие мультики для детей
14.Не умеет водить
15.Не умеет рыбачить
16.Не умеет забивать гвозди
17.Интересуется бабскими штучками
18.Говорит как пидор
19.Не ебал бабу
20.Не может постоять за себя